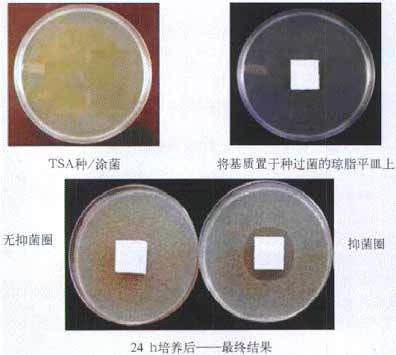
抗菌剂效果2

三氧化二锑替代物 PVC 无卤阻燃剂 PE阻燃母粒,聚丙烯阻燃 ,PP阻燃 ABS阻燃 ,PA 阻燃,PET阻燃 ,PBT阻燃 ,环氧树脂阻燃,玻璃钢抗老化化,POM抗老化,PPO 抗老化,抗静电母粒,阻燃料,抗老化料,环氧树脂抗老化,油漆涂料抗菌防霉 ,化纤纺织阻燃 ,仿真植物抗老化,色母粒 氧化诱导剂,
地址:杭州市萧山区经济开发区红垦农场红泰六路489号
	电话:0571-83532215
传真:0571-82879575
网址:www.hzjwnm.com
			
 
 
1该抗菌剂是由无机系抗菌玻璃微粒子包含着银,锌等抗菌成份并且稳定形态在其中均匀分布,对细菌有优良的抗菌功效,制品因而具有高的安全性,耐热性和稳定性。
2该系列抗菌剂耐水、耐酸碱、耐洗涤,光照不老化,细菌抗药性不易产生。几乎对所有菌种(细菌、真菌、酵母、霉菌、藻类等)均有强的杀灭能力。
1该抗菌剂是由无机系抗菌玻璃微粒子包含着银,锌等抗菌成份并且稳定形态在其中均匀分布,对细菌有优良的抗菌功效,制品因而具有高的安全性,耐热性和稳定性。
2该系列抗菌剂耐水、耐酸碱、耐洗涤,光照不老化,细菌抗药性不易产生。几乎对所有菌种(细菌、真菌、酵母、霉菌、藻类等)均有强的杀灭能力。
3产品符合ISO22196-2011国际标准。
4使用范围及添加量:出口产品推荐添加比例:0.3%
涂料等薄制品添加量0.3%-0.5%
非出口产品添加量:0.2%-0.3%
6颜色和形状:白色微粒子
比表面积:10-12 m2/g
粒子密度:2.54 g.cm2
平均粒径:10 um(另一款产品3um,价格较贵)
	二应该范围
抗菌剂成本是稳定形态的无机氧化物,所以应用前景广泛,用途如下: 
家用电器:洗衣机电冰箱 吸尘器 空调洗碗机 AV机器 电饭煲 手机等
建筑材料 机器设备:浴缸 洗澡间便器 马桶座水池 墙纸内部装饰涂料床垫
厨房用具:餐具托盘 垃圾箱 菜板菜刀 米柜筷子篮子
文具:活心铅笔 圆珠笔 规尺
铁路 汽车:方向盘 扶手 内部用具
其它:化妆品容器衣箱饭盒话筒涂料 陶瓷等
抗菌剂抗菌类型包括:(其中1和2为重点检测细菌)
1金黄色葡萄球菌Staphylococcusaureus(S.a)
2大肠杆菌Escherichiacoli(E.c.)

四:包装方式
抗菌剂粉:有1公斤和20公斤两种包装
抗菌剂母粒:25公斤包装
保质期:36个月
五产品优势
1透明性
在PS AS等透明树脂中添加后不影响透明性
2持续性
抗菌成份以稳定形态氧化物(氧化银)在制品中均匀分布且有持续效果
3低添加率
很低的添加量就能达到效果,从而减少对塑料颜色、性能等造成的影响。
添加高的抗菌剂必然会造成颜色,性能的改变。
4安全性
由于无机系抗菌而有高的安全性
5多样性
调节玻璃组成,能做根据要求的产品
6价格优势
因为添加量,从而减少了成本
7产品通用性
可在PP PE PVC PS ABS等塑料中使用。该产品可以在350度以下的高温中正常使用。
8该产品获美国FDA认证
可以在食品等相关行业应用。
安全性:
符合ROHS指令,无味,无皮肤刺激性,可通过FDA检测
9 产品的抗菌性能具有很长的持效期。
普通PP板经耐水实验后常温72小时、耐光实验后300小时并经抗菌试验后的菌数(cfu/ml)为107,添加0.5%抗菌剂的PP板在同样条件下的菌数测得<10,仍具有十分优异的抗菌性能。
添加该抗菌剂后的制品在多年以上仍然有高的抗菌效果。